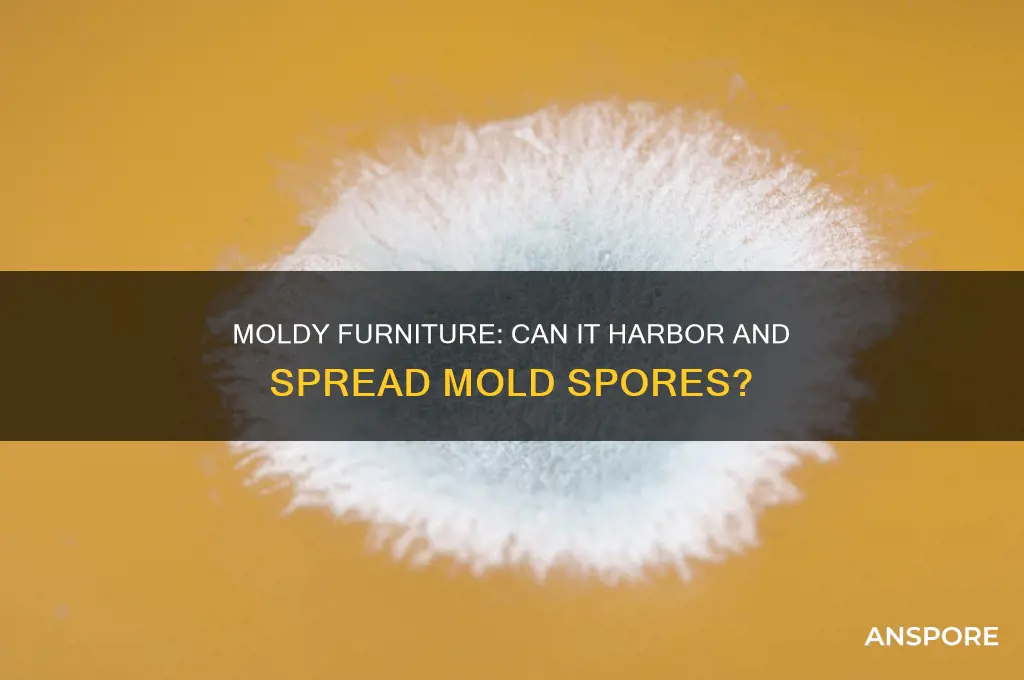
can furniture in a moldy have mold spores

Furniture in a moldy environment is highly susceptible to harboring mold spores, which can pose significant health risks and damage the items themselves. Mold thrives in damp, humid conditions, and porous materials commonly found in furniture, such as wood, fabric, and upholstery, provide an ideal surface for spores to settle, grow, and spread. Even if mold is not visibly present on the furniture, airborne spores from the surrounding environment can easily attach to and colonize these surfaces. Prolonged exposure to mold spores can lead to respiratory issues, allergies, and other health problems, making it crucial to address mold contamination promptly and thoroughly. Regular inspection, proper ventilation, and immediate remediation are essential to prevent mold growth and protect both the furniture and the occupants of the space.
| Characteristics | Values |
|---|---|
| Presence of Mold Spores | Yes, furniture in a moldy environment can harbor mold spores. Mold spores are microscopic and can settle on surfaces, including furniture, even if visible mold is not present. |
| Common Materials Affected | Wood, fabric, upholstery, leather, and other porous materials are particularly susceptible to mold spore accumulation. |
| Conditions Favoring Growth | High humidity (above 60%), poor ventilation, and damp conditions promote mold spore germination and growth on furniture. |
| Health Risks | Exposure to mold spores on furniture can cause allergic reactions, respiratory issues, headaches, and other health problems, especially in sensitive individuals. |
| Detection Methods | Musty odors, visible mold growth, or professional mold testing (e.g., air sampling, surface testing) can confirm the presence of mold spores on furniture. |
| Prevention Measures | Maintain low humidity levels, ensure proper ventilation, promptly address water leaks or moisture issues, and regularly clean furniture to prevent mold spore accumulation. |
| Remediation Steps | For non-porous surfaces, clean with mold-killing solutions (e.g., vinegar, bleach). Porous materials may need professional cleaning or replacement if heavily contaminated. |
| Long-Term Impact | Prolonged exposure to mold spores on furniture can lead to chronic health issues and structural damage to the furniture itself. |
Explore related products
$13.48 $14.13
What You'll Learn
- Mold Growth Conditions: High humidity, warmth, and organic materials foster mold spore development in furniture
- Health Risks: Inhaling mold spores from furniture can cause allergies, asthma, and respiratory issues
- Detection Methods: Visible mold, musty odors, and mold testing kits help identify spores in furniture
- Prevention Tips: Reduce moisture, improve ventilation, and clean furniture regularly to prevent mold growth
- Remediation Steps: Clean moldy furniture with vinegar, bleach, or hire professionals for severe cases

Mold Growth Conditions: High humidity, warmth, and organic materials foster mold spore development in furniture
Mold spores are opportunistic, thriving in environments that meet their basic needs for survival and reproduction. Among the most critical factors are high humidity, warmth, and the presence of organic materials—all of which are commonly found in furniture. Upholstered items, wooden pieces, and even leather goods provide the cellulose and nutrients mold spores crave. When relative humidity exceeds 60%, these spores activate, colonize surfaces, and begin to spread. This isn’t just a theoretical risk; studies show that mold can grow on furniture within 24 to 48 hours under ideal conditions. Understanding these conditions is the first step in preventing mold infestations and protecting both your furniture and your health.
To combat mold growth, controlling indoor humidity is paramount. Invest in a hygrometer to monitor levels, aiming to keep them below 50%. Dehumidifiers are particularly effective in damp areas like basements or climates prone to high moisture. For existing furniture, inspect it regularly for signs of mold, such as musty odors, discoloration, or visible growth. If mold is detected, act swiftly: isolate the piece, ventilate the area, and clean non-porous surfaces with a solution of one cup of bleach per gallon of water. Porous materials like fabric may need professional treatment or replacement, as mold can penetrate deeply, making thorough removal difficult.
Warmth accelerates mold growth, with temperatures between 77°F and 86°F (25°C and 30°C) creating an ideal breeding ground. Furniture placed near heat sources or in poorly ventilated rooms is especially vulnerable. Rearrange your space to ensure air circulates freely around furniture, and avoid overcrowding. In warmer months, use air conditioning or fans to maintain cooler temperatures. For wooden furniture, consider applying mold-resistant finishes or sealants, which act as a barrier against moisture absorption. These proactive measures can significantly reduce the risk of mold taking hold.
Comparing furniture materials reveals varying susceptibility to mold. Wood, while durable, is highly absorbent and prone to mold if exposed to moisture. Upholstered furniture, particularly those with natural fibers, provides both food and habitat for mold spores. Synthetic materials like plastic or metal are less likely to support mold growth but can still harbor spores on their surfaces. The takeaway? Choose materials wisely for high-risk areas, and prioritize maintenance. For instance, leather furniture should be conditioned regularly to prevent cracks where mold can settle, while wooden pieces should be kept dry and well-ventilated.
Finally, prevention is far easier than remediation. Simple habits like wiping down furniture after spills, ensuring proper ventilation, and addressing water leaks immediately can make a world of difference. For those living in humid climates, consider storing valuable furniture in climate-controlled spaces or using moisture-absorbing products like silica gel packets. By understanding and mitigating the conditions that foster mold growth, you can preserve the longevity of your furniture and maintain a healthier living environment. After all, mold doesn’t stand a chance when its ideal habitat is denied.
Understanding Spores and Pollen: Key Differences and Ecological Roles
You may want to see also

Health Risks: Inhaling mold spores from furniture can cause allergies, asthma, and respiratory issues
Furniture exposed to moldy environments often becomes a breeding ground for mold spores, which can detach and become airborne with the slightest disturbance. When inhaled, these microscopic particles pose significant health risks, particularly for individuals with pre-existing conditions or weakened immune systems. Mold spores are not merely allergens; they can trigger a cascade of respiratory issues, from mild irritation to severe complications. Understanding the dangers of inhaling mold spores from furniture is the first step in mitigating their impact on indoor air quality and personal health.
For those with allergies, exposure to mold spores from furniture can lead to symptoms such as sneezing, itching, and nasal congestion. Prolonged or repeated exposure may exacerbate these reactions, making it essential to identify and address mold-infested items promptly. Asthma sufferers are particularly vulnerable, as mold spores can cause airway inflammation and trigger asthma attacks. Studies show that even low levels of mold exposure can worsen asthma symptoms, especially in children and the elderly. Practical steps, such as using HEPA air purifiers and regularly cleaning furniture, can reduce spore concentrations and minimize risks.
Inhaling mold spores can also lead to respiratory infections, particularly in individuals with compromised immune systems. Mold produces mycotoxins, which, when inhaled, can irritate the lungs and lead to conditions like bronchitis or pneumonia. Infants, the elderly, and individuals with chronic illnesses are at higher risk due to their reduced ability to combat infections. To protect these vulnerable groups, it’s crucial to inspect furniture for signs of mold, such as musty odors or visible growth, and take immediate action if detected. Professional mold remediation may be necessary for severe cases to ensure complete removal.
Comparatively, the health risks of inhaling mold spores from furniture are often underestimated when contrasted with other indoor air pollutants like dust or pet dander. However, mold spores are unique in their ability to proliferate rapidly and release harmful substances into the air. Unlike allergens that may cause temporary discomfort, mold exposure can lead to long-term health issues if left unaddressed. For instance, chronic exposure to mold has been linked to the development of hypersensitivity pneumonitis, a serious lung condition. This underscores the importance of treating mold-infested furniture as a priority in maintaining a healthy indoor environment.
To mitigate the health risks associated with mold spores from furniture, proactive measures are essential. Regularly inspect furniture, especially in damp or humid areas, for signs of mold. Use dehumidifiers to maintain indoor humidity below 50%, as mold thrives in moist conditions. If mold is detected, clean non-porous surfaces with a solution of bleach and water, but discard porous materials like upholstered furniture, as they cannot be fully decontaminated. Lastly, ensure proper ventilation in living spaces to reduce spore accumulation. By taking these steps, individuals can protect themselves and their families from the respiratory hazards posed by mold spores in furniture.
Can Antibiotics Kill Spores? Unraveling the Science Behind Resistance
You may want to see also

Detection Methods: Visible mold, musty odors, and mold testing kits help identify spores in furniture
Furniture in moldy environments often harbors hidden mold spores, even if no visible growth is apparent. Mold thrives in damp, humid conditions, and porous materials like wood, fabric, and upholstery provide ideal surfaces for spores to settle and proliferate. Detecting these spores early is crucial to prevent health risks and structural damage. Three primary methods—visible inspection, odor detection, and mold testing kits—offer practical ways to identify mold spores in furniture.
Visible mold is the most straightforward indicator of spore presence. Inspect furniture for discolored patches, fuzzy textures, or black, green, or white spots, particularly in crevices, seams, and underside areas where moisture accumulates. However, absence of visible mold doesn’t guarantee a spore-free environment. Mold can grow beneath surfaces or in microscopic colonies, making deeper investigation necessary. Use a bright flashlight and magnifying glass to scrutinize suspicious areas, and consider removing cushions or upholstery for a thorough examination.
Musty odors often signal mold growth before it becomes visible. Mold releases volatile organic compounds (VOCs) as it metabolizes, producing a distinct earthy or damp smell. If furniture emits this odor, especially after prolonged storage or exposure to moisture, spores are likely present. Trust your sense of smell as an early warning system, but note that odor sensitivity varies among individuals. For a more objective assessment, pair odor detection with other methods, such as testing kits, to confirm spore activity.
Mold testing kits provide a scientific approach to spore detection. Available in home improvement stores or online, these kits typically include swabs, petri dishes, or air sampling cassettes. Follow the manufacturer’s instructions carefully: swab suspicious areas, expose the kit to the air near the furniture, or collect a sample for lab analysis. Results may take 24–48 hours for visible mold growth or require professional interpretation for air samples. While kits offer precision, false negatives can occur if spores are unevenly distributed or if the sample is collected incorrectly. Combine testing with visual and olfactory methods for comprehensive detection.
In summary, detecting mold spores in furniture requires a multi-pronged approach. Visible inspection identifies surface growth, musty odors alert to hidden colonies, and testing kits provide scientific confirmation. Early detection not only protects health but also preserves furniture integrity, as prolonged mold exposure can cause irreversible damage. Regularly inspect high-risk pieces, especially in humid environments, and act promptly at the first sign of spores.
Where to Buy Milky Spore: Top Retailers and Online Sources
You may want to see also
Explore related products

Prevention Tips: Reduce moisture, improve ventilation, and clean furniture regularly to prevent mold growth
Mold spores are everywhere, but they need moisture to thrive. Furniture, especially in damp environments, can become a breeding ground for these spores, leading to mold growth. The key to preventing this lies in controlling the conditions that mold finds favorable. By focusing on reducing moisture, improving ventilation, and maintaining cleanliness, you can significantly lower the risk of mold taking hold on your furniture.
Step 1: Reduce Moisture
Moisture is the primary catalyst for mold growth. Start by identifying and addressing sources of excess humidity in your home. Use a dehumidifier to maintain indoor humidity levels between 30% and 50%, as recommended by the Environmental Protection Agency (EPA). Fix leaks promptly, whether from pipes, roofs, or windows, as even small amounts of water can create a conducive environment for mold. For furniture, avoid placing it against exterior walls or in basements prone to dampness. Instead, opt for well-insulated areas and use moisture-resistant materials for pieces in high-risk zones, like bathrooms or kitchens.
Step 2: Improve Ventilation
Stagnant air traps moisture and creates pockets of humidity where mold can flourish. Enhance airflow by opening windows regularly, especially during dry weather. Use exhaust fans in kitchens and bathrooms to expel humid air, and ensure vents are clear of obstructions. For furniture, avoid overcrowding rooms, as this restricts air circulation. Consider rearranging pieces to allow air to flow freely around and beneath them. In enclosed spaces like closets or storage rooms, use portable fans or leave doors ajar to promote ventilation.
Step 3: Clean Furniture Regularly
Dust and dirt provide organic material for mold to feed on, so regular cleaning is essential. Wipe down furniture surfaces weekly with a microfiber cloth to remove dust and allergens. For deeper cleaning, use a mild detergent mixed with water, ensuring the solution is not overly wet to avoid saturating the material. Upholstered furniture requires special attention—vacuum it monthly and treat stains immediately to prevent moisture absorption. For wooden pieces, apply a protective sealant to create a barrier against moisture. Inspect furniture periodically for signs of mold, such as discoloration or a musty odor, and address any issues promptly.
Cautions and Considerations
While these steps are effective, over-reliance on one method can lead to imbalances. For instance, excessive dehumidification can dry out wood, causing it to crack, while over-ventilation in cold climates may increase heating costs. Always balance these measures with the specific needs of your environment and furniture materials. Additionally, avoid using bleach or harsh chemicals on furniture, as they can damage surfaces and leave residues that attract moisture.
Preventing mold on furniture is a proactive process that combines environmental control with regular maintenance. By reducing moisture, improving ventilation, and cleaning consistently, you create an inhospitable environment for mold spores. These steps not only protect your furniture but also contribute to a healthier indoor space overall. Remember, prevention is always more effective—and less costly—than remediation.
Best Places to Buy Spores: A Comprehensive Guide for Enthusiasts
You may want to see also

Remediation Steps: Clean moldy furniture with vinegar, bleach, or hire professionals for severe cases
Furniture exposed to moldy environments often harbors mold spores, which can spread and grow if left untreated. These spores thrive in damp, humid conditions, making porous materials like wood, fabric, and upholstery particularly susceptible. Addressing mold on furniture promptly is crucial to prevent health risks and further damage.
Step-by-Step Remediation with Household Solutions
For mild to moderate mold cases, vinegar and bleach are effective DIY remedies. White vinegar, a natural antifungal, can be applied undiluted to non-porous surfaces or mixed 1:1 with water for fabrics. Spray the solution, let it sit for an hour, then scrub with a soft brush and wipe dry. Bleach, a stronger option, should be mixed at a ratio of 1 cup per gallon of water. Apply it to non-porous surfaces, let it sit for 15 minutes, then rinse and dry thoroughly. Always test a small area first to avoid discoloration.
When to Call Professionals
Severe mold infestations, especially on antique or valuable pieces, require professional intervention. Signs of severe mold include a musty odor, visible mold colonies larger than 10 square feet, or mold growth inside furniture cavities. Professionals use specialized equipment like HEPA vacuums and commercial-grade fungicides to ensure complete removal. They also address underlying moisture issues to prevent recurrence.
Cautions and Practical Tips
When cleaning mold, wear protective gear—gloves, goggles, and a mask—to avoid spore inhalation. Ensure proper ventilation by opening windows or using fans. Avoid mixing vinegar and bleach, as it produces toxic fumes. For upholstered furniture, consider steam cleaning after treatment to kill residual spores. Regularly inspect furniture in damp areas, such as basements or near windows, to catch mold early.
While vinegar and bleach are effective for minor mold issues, severe cases demand professional expertise. Timely action, proper technique, and preventive measures are key to preserving furniture and maintaining a healthy living environment.
Exploring the Genetic Diversity of Spores: Unveiling Nature's Hidden Complexity
You may want to see also
Frequently asked questions
Yes, furniture in a moldy environment can easily harbor mold spores, as spores are airborne and can settle on surfaces, including furniture, where they may grow if conditions are favorable.
Mold spores are microscopic and travel through the air, settling on surfaces like furniture. In a moldy environment, the high concentration of spores increases the likelihood of them landing and potentially growing on furniture.
Yes, mold spores on furniture can cause health issues, especially for individuals with allergies, asthma, or weakened immune systems. Prolonged exposure to mold spores can lead to respiratory problems, skin irritation, and other health concerns.
To remove mold spores from furniture, clean the surface with a mixture of water and detergent or a mold-specific cleaner. For porous materials, professional cleaning or replacement may be necessary. Additionally, address the underlying mold issue in the environment to prevent recurrence.































